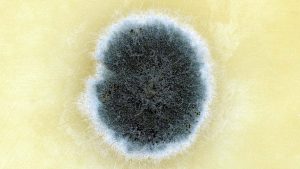

फंगसच्या आत ‘रशियन डॉल व्हायरस’
इंफेक्शन झाल्यास वाचणे अवघड
जागतिक आरोग्य संघटनेने एका फंगसच्या आत रहस्यमय व्हायरस असण्याची शक्यता व्यक्त केली आहे. नव्या अध्ययनातून व्हायरला लक्ष्य करत फंगल इंफेक्शनचा उपचार केला जाऊ शकतो, असे कळले आहे. या व्हायरसचे नाव ए. फुमिगॅट्स पॉलिमायकोव्हायरस-1 आहे. हा फंगस अॅस्परगिलियस फुमिगॅट्समध्ये असू शकतो असा अध्ययनाने खुलासा केला आहे. हा व्हायरस माणसांसाठी आणखी घातक ठरणार आहे.
अॅस्परगिलियस फुमिगॅट्स एक सामान्य फंगस आहे, जो माती, रस्ते आणि हवेत असतो. याचे बिजाणू (स्पोर्स) हवेद्वारे कुठेही पोहोचू शकतात. बहुतांश लोक दैनंदिन या स्पोर्सला श्वासाद्वारे शरीरात घेतात, परंतु स्वस्थ माणसांमध्ये कुठलीच समस्या होत नाही, परंतु कमकुवत इम्युन सिस्टीम असलेले लोक म्हणजेच कॅन्सर, एड्सचे रुग्ण किंवा फुफ्फुसांचे आजार असलेले लोक याचे शिकार ठरतात.
इंफेक्शनचे प्रकार : हा फुफ्फुसांमध्ये शॉर्ट-टर्म किंवा लाँग-टर्म इंफेक्शन निर्माण करू शकतो. सर्वात घातक इनवेसिव एस्परगिलोसिस असून तो फुफ्फुसांमधून फैलावत शरीराच्या अन्य हिस्स्यांमध्ये पोहोचतो. जगभरात दरवर्षी 6.55 दशलक्ष इनवेसिव फंगल इंफेक्शन होतात, ज्यातील 2.1 दशलक्ष इनवेसिव एस्परगिलोसिस आणि 1.8 दशलक्ष क्रॉनिक लंग इंफेक्शनची प्रकरणे असतात.
इनवेसिव इंफेक्शनचा मृत्यूदर 30 ते 80 टक्क्यांपर्यंत आहे. हिब्रू युनिव्हर्सिटी ऑफ जेरूसलेमच्या पोस्टडॉक्टोरल रिसर्चर मारिना कॅम्पोस रोचा यांनी हा फंगस फुफ्फुसांमध्ये घुसून इम्युन सिस्टीमला चकवितो, खासकरून रुग्णालयांमध्ये व्हेंटिलेटरवरील रुग्णांसाठी हा जीवघेणा असल्याचे सांगितले आहे. हा व्हायरस फंगसच्या आत लपलेला असतो. रशियन नेस्टिन डॉलमध्ये एका बाहुलीच्या आत दुसऱ्या बाहुलीप्रमाणे हा प्रकार असतो. या व्हायरससंबंधीचे अध्ययन नेचर मायक्रोबायोलॉजी नियतकालिकात प्रकाशित झाले आहे. यात उंदरांवर प्रयोग करण्यात आला. फंगसला एका रुग्णाच्या फुफ्फुसामधून मिळविण्यात आले, जो एस्परगिलोसिसने मृत्युमुखी पडला होता.
व्हायरसचा प्रकार
एएफयूपीएमव्ही-1एम एक डबल स्ट्रैंडेड आरएनए व्हायरस असून तो पॉलिमायकोरिडी परिवारातील आहे. हा फंगसला संक्रमित करतो, परंतु माणूस किंवा उंदरांना थेट नुकसान पोहोचवित नाही, कारण याकरता विशिष्ट रिसेप्टर्स आणि प्रोटीन हवे असतात, जे माणसांमध्ये नसतात. हा व्हायरस केवळ अॅस्परगिलियस फ्युमिगॅट्सला संक्रमित करू शकतो.
व्हायरसमुळे फंगस मजबूत
अध्ययनातून व्हायरस फंगसला स्ट्रेस सहन करण्यास मदत करतो. फंगस ऑक्सिजन रेडिकल्सशी लढण्यास प्रभावी मदत करतो. उच्च तापमानात (मानवी शरीराच्या 37 अंश) जिवंत राहण्याची क्षमता प्रदान करतो. व्हायरस आरएनए प्रोसेसिंगला नियंत्रित करतो, यामुळे फंगस प्रोटीन चांगले तयार करतो, रिप्रॉडक्शन जलद होते. फंगसमध्ये मेलानिन कमी तयार होते ,जे वायरुलेंस (रोग निर्माण करण्याची क्षमता) वाढविते. कठोर वातावरणात जिवंत राहण्यास मदत करते. मानवी इम्यून सेल्स (उदारहणार्थ मॅक्रोफेज) व्हायरस-संक्रमित फंगसला मारण्यास असमर्थ ठरू लागतात.